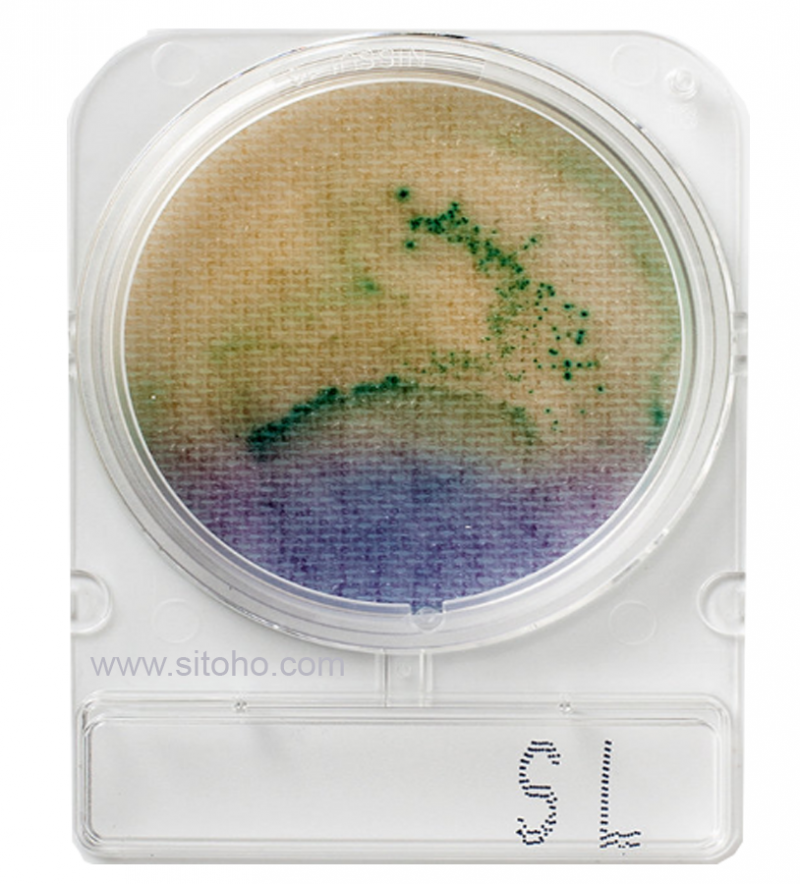

Alat Uji Bakteri Ecoli, Coliform dan Salmonella (Microbiology Food and Water Test Kit)
Dapatkan Spesifikasi Harga Alat Uji Bakteri Ecoli, Coliform dan Salmonella (Microbiology Food and Water Test Kit) Produk Terbaik dari
Alat Ukur Environmental Menjual Alat Laboratorium Kesehatan Lingkungan
Produk Detail
Test Kit E-Coli Coliform dan Salmonella atau Microbiology Food and Water Test Kit type BAC-002-S merupakan alat uji untuk pemeriksaan kadar bakteri pada sampel makanan dan minuman. Microbiology Food and Water Test Kit sangat cocok dipergunakan untuk pemeriksaan pada jajanan anak sekolah, Kantin, Pasar, Usaha Katering, Makanan Pesta, Makanan Bergizi Gratis (MBG), Makanan VVIP agar terhindar dari penyakit akibat makanan mengandung bakteriMicrobiology Food and Water Test Kit
Type : BAC-002-S
Specification :
| A | Test Kit Uji Bakteri : | ||
| 1 | Uji bakteri E-Coli dan Coliform | ||
| ▪ | Detection Parameter | : | E-coli and Coliform |
| ▪ | Input tube | : | Single tube photometer |
| ▪ | Excitation Wavelength | : | 360nm and 480nm |
| ▪ | Emission Wavelenth | : | 460nm and 530nm |
| ▪ | Read Type | : | Discrete |
| ▪ | Sample Volume | : | 500 μl Centrifuge tube |
| ▪ | Dinamic range | : | 5 order of magnitude |
| ▪ | Read out | : | RFU |
| ▪ | User interface | : | User-Friendly Touch Screen LCD |
| ▪ | Power | : | 4AA Batteries |
| ▪ | Computer interface | : | USB interface |
| ▪ | Media | : | Growth Media Powder (Ecoli - Total Coliform) |
| ▪ | Vial Sample | : | 2x50 pcs, cap. 0,1-1,5 ml |
| ▪ | Plastic vial sample | : | 2x50 pcs, capacity 0,6 ml |
| ▪ | Substrance | : | Reagent A, min. 4 ml |
| ▪ | Enzym Inducer | : | Reagent B, min. 2ml |
| ▪ | Packing | : | Hard case |
| 2 | Test Kit Uji Salmonella | : | 240 test |
| Uji bakteri siap pakai tersedia bantalan nustrisi pada cawan perti dish | |||
| 3 | Perlengkapan | ||
| ▪ | Tabung Penyaring Sampel | : | 240 pcs |
| lengkap dengan filter 47mm, 0.45uM | |||
| ▪ | Spuit 100 ml | : | 6 pcs |
| ▪ | Aquades 500ml | : | 2 botol |
| ▪ | Plastik sample (pack/100pcs) | : | 1 pack |
| B | Peralatan Pendukung | ||
| 1 | Cool Box capacity 20 L | : | 1 unit |
| 2 | Blue Ice Pack 22x15x3cm | : | 4 pcs |
| 3 | colony Counter | ||
| ▪ | Display | : | LCD 3 digits |
| ▪ | Lighting | : | Matrix LED (white light) |
| ▪ | Capacity of the Counter | : | 0-999 |
| ▪ | Diameter of the counting plate | : | Φ 115 mm |
| ▪ | Power consumption of lamp | : | 3-9 times |
| ▪ | Magnification | : | 16 W |
| ▪ | Total power consumption | : | <20 W |
| ▪ | Voltage | : | AC220V, 50/60Hz |
| ▪ | Volume / weight | : | 225 x 210 x 160mm / 2.2 kg |
| 4 | Portable Incubator | ||
| ▪ | Temperature range | : | +5 to 70°C |
| ▪ | Temperature Resolution ratio | : | 0,1 °C |
| ▪ | Temperature Control Mode | : | PID intelligent |
| ▪ | Capacity | : | 9,2 L |
| ▪ | Inner Chamber | : | Mirror stainless steel |
| ▪ | Insulation layer | : | Polyurethane |
| ▪ | Heater | : | Heating wire |
| ▪ | Timer | : | 0-9999 min |
| ▪ | Temp setting mode | : | Touch button setting |
| ▪ | Temp display mode | : | Measuring temp, LED upper row |
| ▪ | Shelf number | : | 4 |
| ▪ | Safety device | : | Over Temperature sound-light alarm |
| ▪ | Power | : | AC 220V (50/60hz) |
| ▪ | Size | : | 300 x 330 x 330cm (external) |
| : | 230 x 200 x 200 cm (inner chamber) | ||
-
Rak Tabung Reaksi Stainless | 12 lubang Diameter 18mm
-
Binocular Compound Microscope Type 1305B | Microscope Compound
-
Binocular Stereo Microscope | Microscope Stereo
-
Binocular Stereo Microscope | Microscope Stereo
-
Entomology Kit (Insect Study) | Alat identifikasi serangga
-
Entomologi Kit ENTOKIT-20 | Alat Pengambilan Sampel Pinjal dan Jentik Nyamuk
-
Rapid Food Test Kit | Food Security Kit SAFE-02 | Alat Deteksi Makanan Beracun
-
SANITARIAN KIT SANPUS D-23P | SANITARIAN KIT UNTUK PUSKESMAS
-
RAPID FOOD TEST KIT SAFE-MBG | FOOD SECURITY KIT | TEST KIT MAKANAN SAFE-MBG
-
Photometer Sanitarian Kit | Photometer Prime Lab 2.0 Water Id